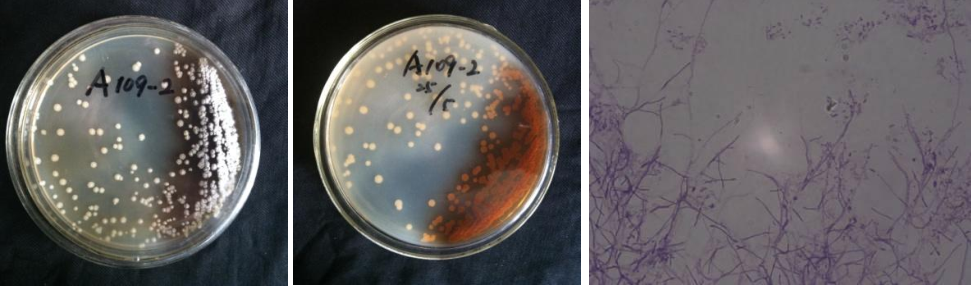

Loading...
| StrainNO | A109 |
| Classification | Actinomyces |
| 16s rDNA sequence | GACGAACGCTGGCGGCGTGCTTAACACATGCAAGTCGAACGGGATCCTTATCCGCTTGCGGGTTTGGTGAGAGTGGCGAACGGGT GAGTAACACGTGAGTAACCTGCCCCCTTCTTTGGGATAACTGCCGGAAACGGTGGCTAATACTGGATATTCAGCACTGGTCGCAT GGTTGGTGTTGGAAAGGTTTTTCTGGTGGGGGATGGGCTCGCGGCCTATCAGCTTGTTGGTGGGGTGATGGCCTACCAAGGCTTT GACGGGTAGCCGGCCTGAGAGGGTGACCGGCCACACTGGGACTGAGACACGGCCCAGACTCCTACGGGAGGCAGCAGTGGGGAAT ATTGCACAATGGGGGAAACCCTGATGCAGCGACGCCGCGTGAGGGATGACGGCCTTCGGGTTGTAAACCTCTTTCAGTAGGGAAG AATTTAGACGGTACCTGCAGAAGAAGCGCCGGCTAACTACGTGCCAGCAGCCGCGGTAATACGTAGGGCGCAAGCGTTGTCCGGA ATTATTGGGCGTAAAGAGCTCGTAGGCGGCTTGTCGCGTCTGTCGTGAAAACCTGCAGCTTAACTGTGGGCTTGCGGTGGGTACG GGCTGGCTTGAGTGCAGTAGGGGAGACTGGAATTCCTGGTGTAGCGGTGGAATGCGCAGATATCAGGAGGAACACCGGTGGCGAA GGCGGGTCTCTGGGCTGTTACTGACGCTGAGGAGCGAAAGCATGGGGAGCGAACAGGATTAGATACCCTGGTAGTCCATGCCGTA AACGTTGGGCACTAGGTGTGGGGACCAGTTCCATGGTTTCTGTGCCGTAGCTAACGCATTAAGTGCCCCGCCTGGGGAGTACGGC CGCAAGGCTAAAACTCAAAGGAATTGACGGGGGCCCGCACAAGCGGCGGAGCATGCGGATTAATTCGATGCAACGCGAAGAACCT TACCAAGGCTTGACATACACCGGAATGCTGCAGAGATGTGGCAGCCTTTGGGCTGGTGTACAGGTGGTGCATGGTTGTCGTCAGC TCGTGTCGTGAGATGTTGGGTTAAGTCCCGCAACGAGCGCAACCCTTGTCTCATGTTGCCAGCACGTGATGGTGGGGACTCATGA GAGACTGCCGGGGTTAACTCGGAGGAAGGTGGGGATGACGTCAAATCATCATGCCCCTTATGTCTTGGGCTTCACGCATGCTACA ATGGCCGGTACAGTGGGTTGCGATCTCGTGAGGGGGAGCTAATCCTTGAAAGCCGGTCTCAGTTCGGATTGGGGTCTGCAACTCG ACCCCATGAAGTCGGAGTCGCTAGTAATCGCAGATCAGCAACGCTGCGGTGAATACGTTCTCGGGCCTTGTACACACCGCCCGTC ACGTCACGAAAGTTGGTAACACCCGAAGCTCATGGCCTAACCCTTTGGGGGGGAGTGGTCGAAGGTGGGACTGGCGATTGGGACG AAGTCGTAACAAGGTAGCCGTACCGGAA |
| Strain Morphology Photos | |
| Morphological Description | The morphology of strain:hyphae branch;Septum;hyphae thicker;spore filaments stubby;tip forming an enlarged spore;Very few milky spore piles;mostly bald;back brownish red |